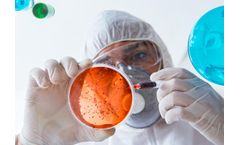
WHS - Water Hygiene Services

- Home
- Services
Refine by
Whs Environmental Industry Services
3 services found
Manufactured by:Water Hygiene Systems Ltd. (WHS) based inLondon, UNITED KINGDOM
At Water Hygiene Systems we offer a full water quality assurance service for small business, public organisations and major ...
Manufactured by:Water Hygiene Systems Ltd. (WHS) based inLondon, UNITED KINGDOM
We are a specialist provider of chemical analysis and treatment of closed water systems. Our Water Treatment Technical Consultants offer advice and services covering, maintenance, treated water and raw water analysis. Regular analyses of systems, along with adjustments to the treatment regime, are carried out by our consultants to provide customers with a quality ...
Manufactured by:Water Hygiene Systems Ltd. (WHS) based inLondon, UNITED KINGDOM
At Water Hygiene Systems we offer a simple testing and analysis service for small business, public organisations and major ...